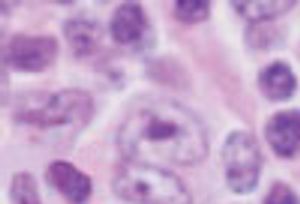

A 56-year-old man presented to the emergency department with a 1-week history of dark-colored urine and acholic stools followed by 3 days of intermittent right upper quadrant abdominal pain and overt jaundice. He had been healthy and did not smoke or drink alcohol. His family history was unremarkable. He recently lost 15 lb and experienced early satiety and intermittent night sweats.